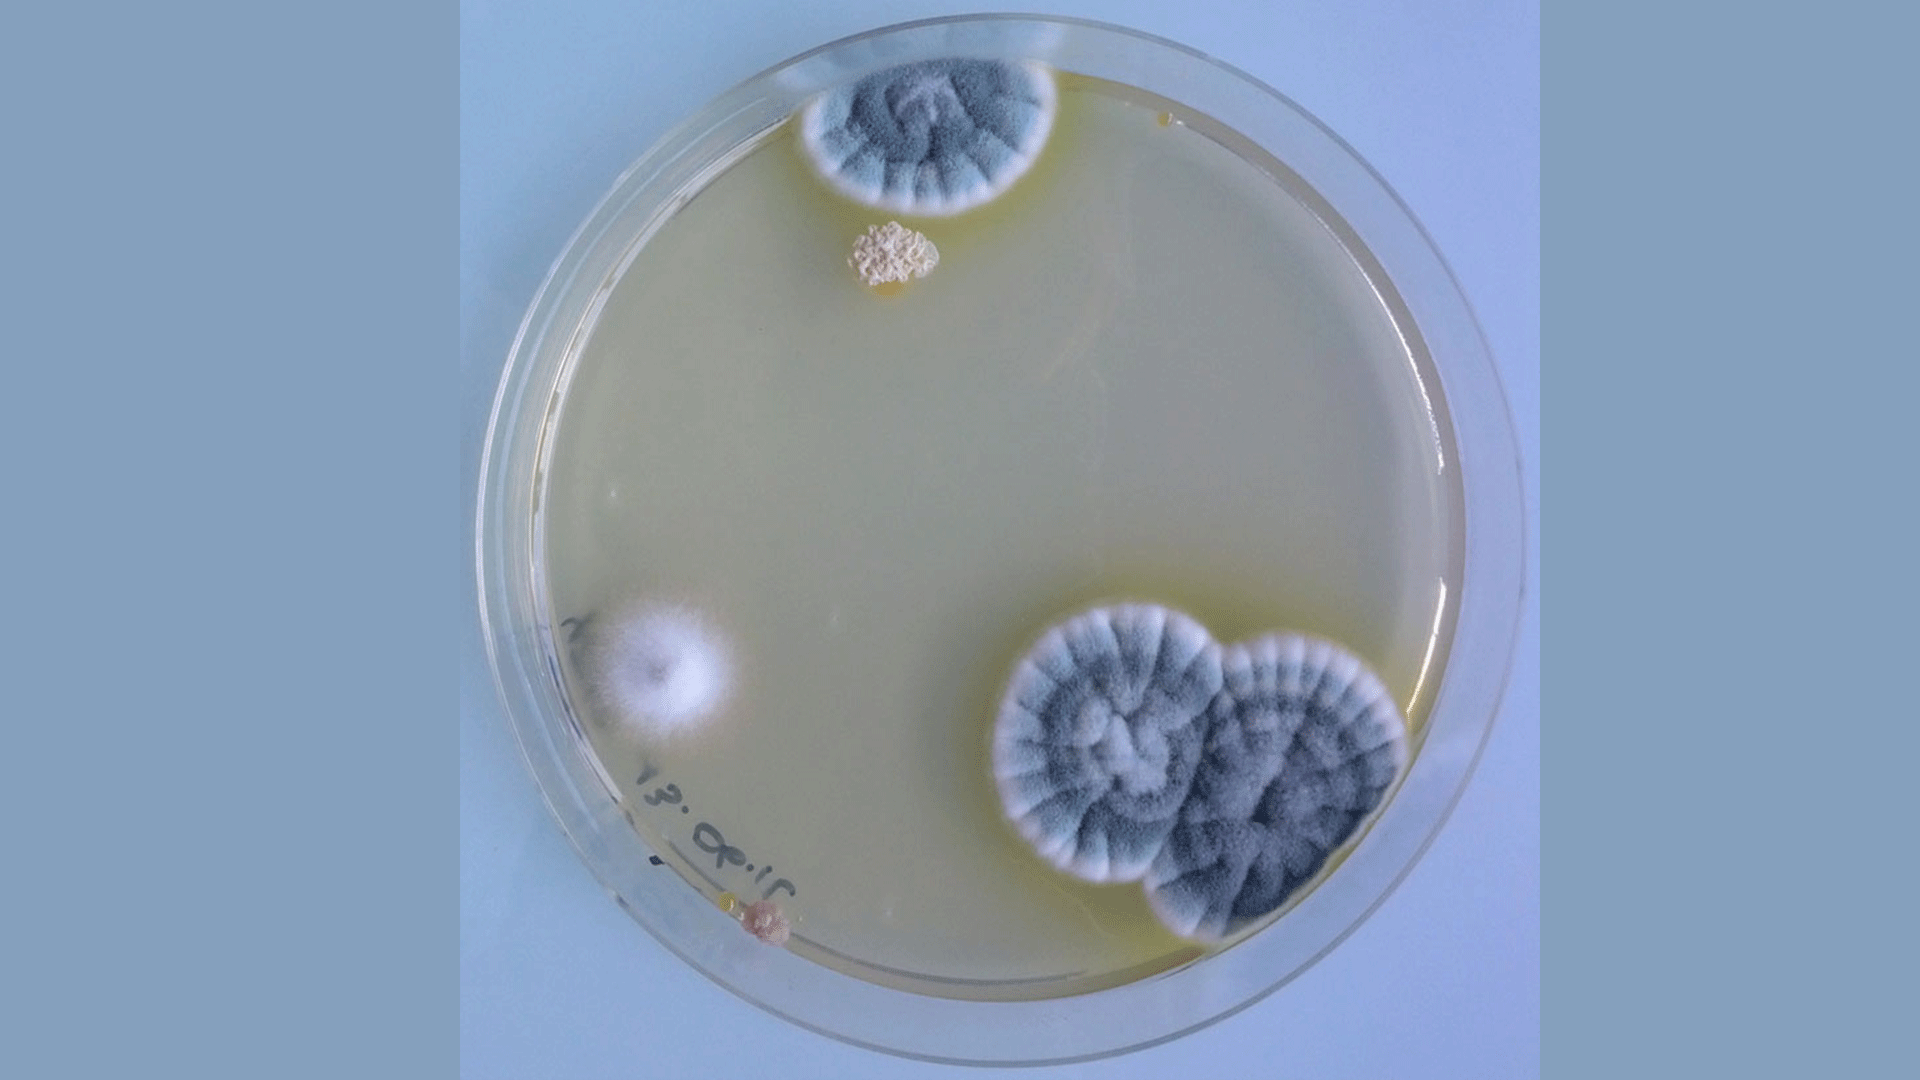

C’est avec une immense tristesse que nous avons appris le décès brutal d’Antoine Bridier-Nahmias dans sa 38ème année, survenu le 24 Avril 2024.
Après des études de Génétique et Biochimie à l’Université Paris 6, Antoine avait brillamment obtenu sa thèse de Sciences en 2014 dans l’UMR 944 Pathologie et Virologie Moléculaire sur le campus Saint Louis avec un travail de recherche sur les rétrotransposons des levures. Il a ensuite fait un passage apprécié dans le Laboratoire de Génomique Bioinformatique et Applications au Conservatoire National des Arts et Métiers lors d’un stage post-doctoral. Il avait été recruté à l’UFR de Médecine de l’Université Paris 7 comme Maitre de Conférences en Biochimie et Bioinformatique en 2016. La particularité de son poste était qu’il enseignait dans les UFR de Médecine et de Sciences de l’Université Paris Cité. Chercheur dans l’UMR 1137 IAME sur le site Bichat, il était devenu un spécialiste reconnu de l’évolution des virus et des bactéries à travers l’étude de leurs génomes.
Passionné aussi bien par l’enseignement que la recherche, toujours jovial, plein d’humour et de bienveillance, Antoine va énormément manquer à ses étudiants et collègues. Transmettre ses connaissances était essentiel pour lui et cela transparaissait dans ses enseignements et ses échanges collaboratifs. Il restera dans l’esprit de tous ceux qui l’ont côtoyé comme un homme chaleureux, brillant, créatif, étonnamment curieux, et animé par l’envie de faire avancer la recherche et de découvrir des mondes nouveaux.
À lire aussi

Les bactériophages, vers une alternative ciblée aux antibiotiques
Avec l’essor des antibiotiques dans les années 1930, la phagothérapie a été abandonnée. Aujourd’hui, la montée de l’antibiorésistance rend le traitement des infections bactériennes de plus en plus difficile et la phagothérapie suscite à nouveau l’intérêt des médecins et des chercheurs, malgré sa complexité de mise en œuvre due à la très grande diversité et spécificité des bactériophages. Lire la suite Les bactériophages, vers une alternative ciblée aux antibiotiques

En images : le 2ème forum des carrières scientifiques et des métiers de la santé
Le forum, qui s’est tenu les 8 et 9 novembre 2024, a débuté par une journée dédiée aux visites scolaires avant d’accueillir le grand public le lendemain. Co-organisé par l’université, l’AP-HP et la Ville de Saint-Ouen, cet événement avait pour objectif de promouvoir les filières scientifiques et de santé ainsi que leurs débouchés auprès des collégiens et lycéens de Seine-Saint-Denis. Lire la suite En images : le 2ème forum des carrières scientifiques et des métiers de la santé

7e États Généraux de la Formation et de la Recherche Médicales : un Rendez-vous National et International
Les 7 et 8 novembre 2024, l’Université Paris Cité a accueilli pour la deuxième fois les États Généraux de la Formation et de la Recherche Médicales, un événement organisé par l’UFR de Médecine de l’Université Paris Cité au nom de la Conférence des Doyens des Facultés de Médecine. Lire la suite 7e États Généraux de la Formation et de la Recherche Médicales : un Rendez-vous National et International

Cérémonie de remise des diplômes de la première promotion fusionnée de DFASM3 à l’UFR de Médecine : Un moment solennel et émouvant
Le mardi 1er octobre a marqué une étape cruciale dans la vie de nombreux étudiants en médecine, avec la cérémonie de remise des diplômes de la première promotion fusionnée de DFASM3 (Diplôme de Formation Approfondie en Sciences Médicales). Lire la suite Cérémonie de remise des diplômes de la première promotion fusionnée de DFASM3 à l’UFR de Médecine : Un moment solennel et émouvant